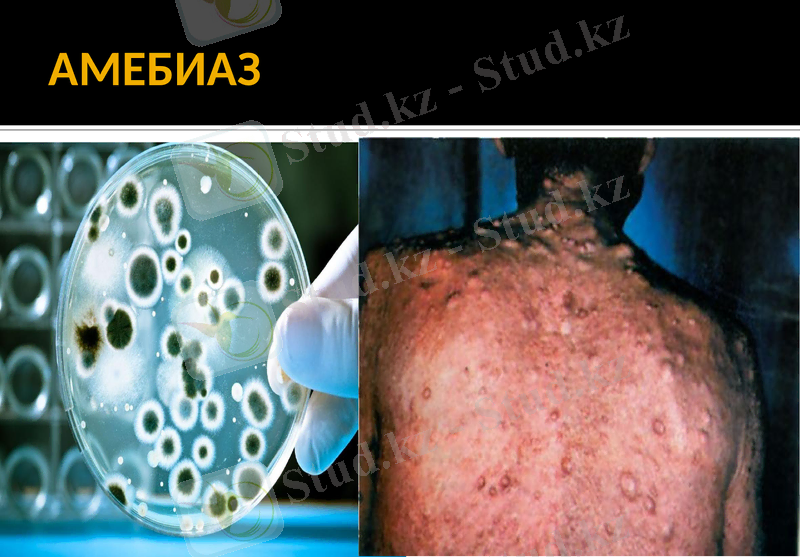
Slide 24

Паразитарлық аурулар хирургиясы: негізгі түрлері, патогенезі және емдеу әдістері



Паразитарлық аурулар хирургиясы және оның негіздері
Орындаған: Рахманберді Ж.
Тобы: М-201-11
Қабылдаған: Жарманов С.

Жоспар
Кіріcпе.
Негізгі бөлім.
1) Эхинококкоз,
2) Альвеококкоз
3) Аскаридоз,
4) Описторхоз
, 5) Амебиаз
6) Филяриатоз
Қорытынды.
Қолданылған әдебиеттер.

Ауданымызда жиі кездесетін құрттар.
Адамда
Жануарда
Үшкірқұрт
Миқұрт
Ішексорғы
Таспасорғыш
Эхинококк
Айырдене
Сиыр цепені
Қылқұрт
Мысық сорғыш құрт
Эхинококк

Адамға жұғу жолдары

Паразитарлы аурулар
Адам денесінде 150-ге жуық паразитарлы құрттар
мен олардың жұмыртқалары өмір сүре алады. Оның
ішінде эхинококкоз, альвеококкоз, аскаридоз, амеби-
аз және описторхоз ауруларын тудыратын паразит-
тердің орны ерекше.


ЭХИНОКОККОЗ

ЭХИНОКОККОЗ
ЭХИНОКОККОЗ-бұл Қазақстанның эндемиялық аймақтарында кең таралған, медициналық және ауылшаруашылық салаларының қатерлі және ауыр паразитарлы дерті болып табылады. Бұл ауруды таспалы құрт-эхинококк(Echinococcus granulosus) шақырады. Эхиноккоздың эпидемиологиялық жағдайы мал шаруашылығы дамыған кең тараған аймақтарда қауіп төндіреді. Көбінесе бауырды(60-85%), өкпені(15%) зақымдайды.

Эхинококктың жұғу жолдары мен оның дамуы
Эхинококк денеге 3 жолмен жұғуы мүмкін:
Асқазан-ішек жолдарының шырышты қабығы арқылы.
Тыныс жолдары арқылы.
Жараның беті арқылы.


эхинококк
Эхинококк құртынан туатын аурудан 2002-2006 жылдар аралығында жалпы 4 ересек адам ауырды.
Жалпы эхинококк құртынан болған аурулар 0, 92 %-тін құрайды. Бұдан 4 адам ауырғанын азғантай деп санауға болмайды. Себебі, олар адамның ең негізгі мүшелерде мекен етіп, бір жылда 400 000 000 жұмыртқа салаты-нын еске тұтқан жөн.
жалпы-4 адам
0, 92%

Эхинококкоздың емі
Хирургиялық операция-қазіргі кездегі эхинококктың бірден-бір емі. Оның ашық, жартылай жабық және жабық түрлерін ажыратады, сонымен қатар эхинококкты кистасы бар ағзаны түгел алып тастайды немесе оның резекциясын жасайды.

Эхинококкоздың емі
Химиялық емі:
Мебендазол- күніне 200мг/кг-нан, 15-24 ай бойы
Альбендазол-тәулігіне 10мг/кг-нан28 күн қабылдап, арасында 14 күн үзіліс жасайды, емнің ұзақтығы 18 айға созылады.
Бильтрацид-тәулігіне 75-150 мг-нан ішке тағайындайды.

АЛЬВЕОКОККОЗ

АЛЬВЕОКОККОЗ
Альвеококкоз-Alveococcus multilocularis дернәсілімен бауырдың біріншілік зақымдалуын шақыратын, паразитарлы ауру болып табылады. Ол ұсақ кисталардың түзілуімен және инфильтративті өсуімен сипатталады.

Альвеолярлы эхинококкоздың клиникалық жіктелуі

Хирургиялық операцияның түрі
Радикальді операциялар.
Шартты түрде радикальді операциялар.
Паллиативті опеарациялар.
Асқынуларды жоюға арналған операциялар.

АСКАРИДОЗ

АСКАРИДОЗ
Аскаридоз-жұмыр құртты аскаридамен шақырылады. Ол қос жынысты. Адамның жіңішкеішегінде өмір сүреді, дамуында өте күрделі миграциялық айналымды өтеді және өмір сүруі бір жылдан аспайды. Адамға алиментарлы жолмен жұғады.
Аскаридоздың патогенезінде екі кезеңді ажыратады:
1) Ерте кезең-миграциялық
2) Ішектік кезең

Аскаридоздың емі
Хирургиялық асқынулар пайда болса, хирургиялық операциялар орындалады-колотомия, ішектің түйілуін жою, перворациялық тесікті тігу, құрсақ қуысын тазарту, дренаж қою, аппендэктомия, дивертикулэктомия. Операциямен бірге дегельминтизация шаралары жүргізіледі.

ОПИСТОРХОЗ

ОПИСТОРХОЗ
Описторхоз- гепатобилиарлы жүйе мен ұйқы безінің гельминтозы болып табылады, Бұл ауру сібірлік Opisthorchis felineus қоздырады. Адамға шикі немесе шала пісірілген, нашар тұздалған балықты жегенде алиментарлы жолмен жұғады. Паразиттер өт жолдары мен ұйқы безінің өзектерінің эпителиалды қабатын зақымдайды олардың бітелуін шақырады . Осының нәтижесінде дискинезия, холангит, холецистит, гепатит дамиды.

ОПИСТОРХОЗДЫҢ ЕМІ
Консервативті емі-антипаразитарлы дәрілер тағайындайды.
Хирургиялық асқынулары дамыса операция орындалады.
АМЕБИАЗ

АМЕБИАЗ
Қоздырғышы-Инфекция көзі-адам болып табылады. Амебалар адамға ауыз арқылы жұғады. Қолайсыз жағдайларда амебалар ішектің қабырғасына еніп көбейіп протеолиттік ферменттерді бөледі де, тіндердің өлі еттенуін шақырады. Ойық жаралар пайда болады, амебомалар түзіледі.
Емі- хирургиялық опеарация, антипаразитарлы дәрілер тағайындалады.

ФИЛЯРИАТОЗДАР
Филяриатоз-филяриялармен қоздырылады. Құрттардың дернәсілі қоршаған ортадан денеге түсіп, ішек арқылы қан айналымына өтеді де, ары қарай өсіп жетіледі. Қан айналымында жүріп лимфа тамырларына түседі де, оларда қабыну үрдісі мен лимфoстазды тудырады, нәтижесінде аяқта пілаяқтық пайда болады.


Филяриатоздардың түрлері
1) Вухериоз 5) Лоалоз
2) Бругиоз 6) Дилеталонематоз
3) Онхоцеркоз 7) Мансонеллез
4) Стрептоцеркоз

Филяриатоздардың емі
Аурудың алғашқы сатыларында антипаразитарлы дәрілер-дитразин цитаты тағайындалады.
Екіншілік инфекцияда антибактериальды ем жүргізіледі.
Асқынулар дамыса хирургилық ем жүргізіледі.

Адам ағзасына паразит құрттар өте қауіпті
Паразит құрттардан сақтанып жүру керек.
- Іс жүргізу
- Автоматтандыру, Техника
- Алғашқы әскери дайындық
- Астрономия
- Ауыл шаруашылығы
- Банк ісі
- Бизнесті бағалау
- Биология
- Бухгалтерлік іс
- Валеология
- Ветеринария
- География
- Геология, Геофизика, Геодезия
- Дін
- Ет, сүт, шарап өнімдері
- Жалпы тарих
- Жер кадастрі, Жылжымайтын мүлік
- Журналистика
- Информатика
- Кеден ісі
- Маркетинг
- Математика, Геометрия
- Медицина
- Мемлекеттік басқару
- Менеджмент
- Мұнай, Газ
- Мұрағат ісі
- Мәдениеттану
- ОБЖ (Основы безопасности жизнедеятельности)
- Педагогика
- Полиграфия
- Психология
- Салық
- Саясаттану
- Сақтандыру
- Сертификаттау, стандарттау
- Социология, Демография
- Спорт
- Статистика
- Тілтану, Филология
- Тарихи тұлғалар
- Тау-кен ісі
- Транспорт
- Туризм
- Физика
- Философия
- Халықаралық қатынастар
- Химия
- Экология, Қоршаған ортаны қорғау
- Экономика
- Экономикалық география
- Электротехника
- Қазақстан тарихы
- Қаржы
- Құрылыс
- Құқық, Криминалистика
- Әдебиет
- Өнер, музыка
- Өнеркәсіп, Өндіріс
Қазақ тілінде жазылған рефераттар, курстық жұмыстар, дипломдық жұмыстар бойынша біздің қор #1 болып табылады.



Ақпарат
Қосымша
Email: info@stud.kz